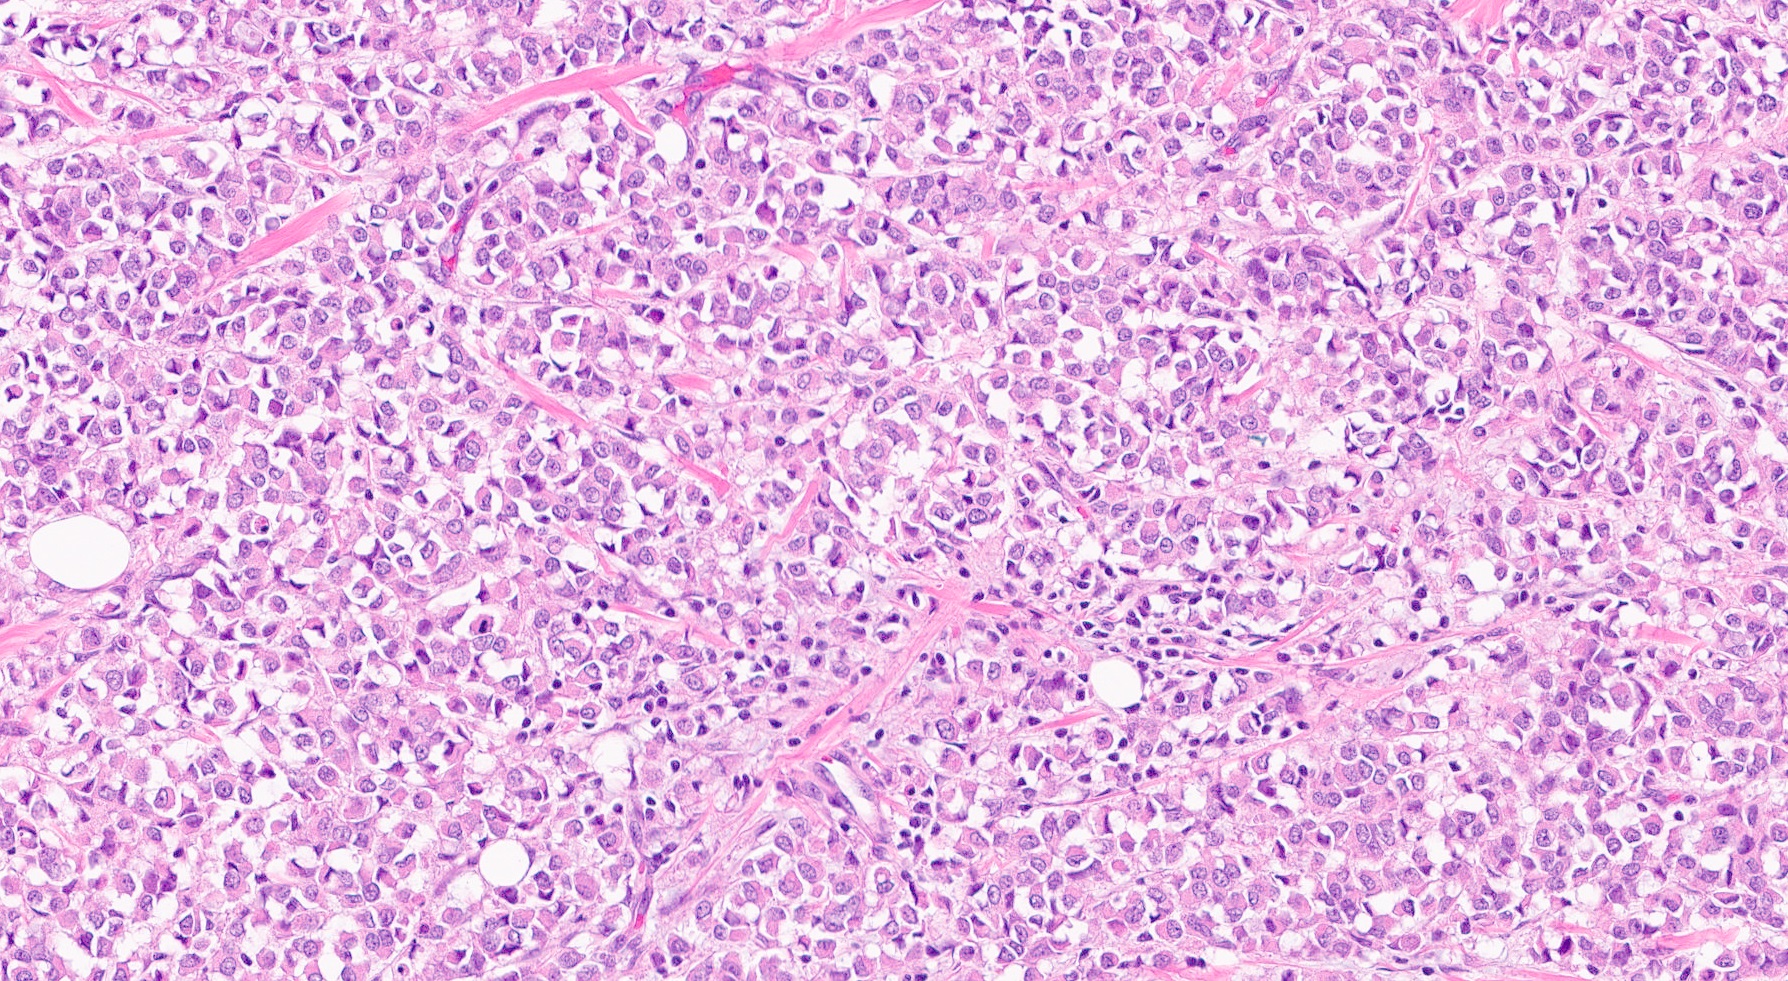

Table of Contents
Definition / general | Essential features | Terminology | ICD coding | Epidemiology | Sites | Etiology | Clinical features | Diagnosis | Radiology description | Radiology images | Prognostic factors | Case reports | Treatment | Clinical images | Gross description | Gross images | Frozen section description | Frozen section images | Microscopic (histologic) description | Microscopic (histologic) images | Virtual slides | Cytology description | Cytology images | Positive stains | Negative stains | Molecular / cytogenetics description | Sample pathology report | Differential diagnosis | Practice question #1 | Practice answer #1 | Practice question #2 | Practice answer #2Cite this page: Li JJX, Tse GM. Invasive lobular carcinoma classic. PathologyOutlines.com website. https://www.pathologyoutlines.com/topic/breastmalignantlobularclassic.html. Accessed September 25th, 2025.
Definition / general
- Invasive breast carcinoma with loss of cellular adhesion, characteristically arranged in discohesive or single file patterns
Essential features
- Special subtype of invasive breast carcinoma characterized by discohesive tumor cells arranged in single files or as individual single cells
- Shows 16q loss (CDH1 gene located at 16q22.1 encodes E-cadherin, integral in formation of adherens junction responsible for cell adhesion)
- Loss of E-cadherin expression on immunohistochemistry helpful but not required for diagnosis
Terminology
- Invasive lobular carcinoma, classic type
ICD coding
- ICD-O: 8520/3 - lobular carcinoma, NOS
- ICD-11: 2C61.1 & XH2XR3 - invasive lobular carcinoma of breast & lobular carcinoma, NOS
Epidemiology
- Comprises about 10% of invasive breast carcinomas (Breast Cancer Res 2015;17:37)
- Most common special subtype of invasive breast carcinoma (Br J Cancer 2005;93:1046)
- Only comprises 1% of male breast carcinomas (Breast Cancer (Dove Med Press) 2017;9:337)
- Mean age of diagnosis is 63.4 years, higher than that for invasive breast carcinoma of no special type (Br J Cancer 2005;93:1046)
- Endogenous (lower parity, younger age at menarche and later menopause) and exogenous (hormone replacement therapy and oral contraceptives) estrogen exposure increases risk (Breast Cancer Res 2015;17:37)
- Alcohol consumption and obesity are risk factors, which may be mediated by increased levels of circulating estrogen
- 60% lifetime risk in women with hereditary diffuse gastric cancer syndrome (germline CDH1 mutation) (J Med Genet 2010;47:436)
- Under represented in breast carcinomas of BRCA1 carriers (2.2%) and similar proportion BRCA2 carriers (8.4%) (Cancer Epidemiol Biomarkers Prev 2012;21:134)
Sites
- Breast
- Can occur in axilla accessory breast tissue
Etiology
- Invasiveness and loss of cellular cohesion due to abnormalities of the adherens complex, formed by cadherins and catenins (Biochim Biophys Acta 2008;1778:660)
- Majority of lobular carcinomas show loss of E-cadherin expression (Am J Surg Pathol 2010;34:1472)
- α, β and γ catenins and p120 expression can be aberrant in E-cadherin positive lobular carcinomas (Am J Surg Pathol 2010;34:1472)
- Lobular carcinoma in situ is a risk factor and nonobligate precursor of invasive lobular carcinoma
Clinical features
- Presents as vague findings including thickening, induration or poorly defined breast mass (Breast Dis 2008-2009;30:31)
- Overall, diagnosed at a more advanced stage than invasive breast carcinoma of no special type (Br J Cancer 2005;93:1046)
- More frequently bilateral and multifocal / multicentric (Breast 2018;38:101, Ann Surg Oncol 2020;27:4711)
- Leptomeningeal spread, cerebrospinal fluid, gastrointestinal tract, uterus and ovary and peritoneal metastasis more common in lobular carcinoma compared with other subtypes (AJR Am J Roentgenol 2000;175:795)
Diagnosis
- Mainly histological or radiological
Radiology description
- Ultrasound (Radiographics 2009;29:165)
- Hypoechoic mass with spiculated or ill defined margins and posterior acoustic shadowing
- Mammography (Radiographics 2009;29:165)
- Does not consistently present as a mass (44% - 65%)
- Less commonly manifests as architectural distortion
- Microcalcification infrequent
- Magnetic resonance imaging findings similar (Radiographics 2009;29:165)
- Can aid in identifying multifocal or residual disease
- Preoperative breast MRI may improve surgical planning (Breast J 2016;22:143)
Radiology images
Prognostic factors
- Older age, larger tumor size and metastatic axillary lymph node involvement are independent risk factors for survival and recurrence (Cancer 2008;113:1511)
- Higher histological grade is associated with poorer outcome (Breast Cancer Res Treat 2008;111:121, Histopathology 2015;66:409)
- Independently predicts shorter disease specific survival and disease free interval
- Associated with higher stage and hormone receptor negativity
- Classic type more favorable than solid, pleomorphic and other types (Cancer 2008;113:1511)
- Lower number of lymph node metastases and risk of recurrence
- E-cadherin negative lobular carcinomas have a higher disease specific mortality than E-cadherin positive counterparts (Histopathology 2015;66:409)
- High Ki67 index associated with risk of distant metastasis (Cancer 2008;113:1511)
- Better initial outcome but worse long term (> 10 years after diagnosis) survival compared with invasive ductal carcinoma (Eur J Cancer 2008;44:73)
Case reports
- 55 year old woman with vague thickening and negative mammography and ultrasound (Clin Case Rep 2019;7:442)
- 73 year old man with invasive lobular carcinoma (Radiol Case Rep 2020;15:727)
- 73 year old woman with diffuse gastrointestinal metastasis 15 years after mastectomy for lobular carcinoma (Oxf Med Case Reports 2019;2019:omy133)
- 76 year old woman presenting with carcinoma en cuirasse (BMJ Case Rep 2017;2017:bcr2017222121)
Treatment
- Mastectomy may be preferred over breast conservation due to risk of local recurrence (Breast 2003;12:23)
- Lobular carcinomas likely to have positive margins on initial excision but risk of recurrence not increased if final margins are clear (Breast Cancer Res Treat 2015;149:555)
- Efficacy of chemotherapy may be limited
- Low rates of successful breast conservation after neoadjuvant chemotherapy (Ann Surg Oncol 2009;16:1606)
- Pathological complete response rate low (14%) (Am J Surg 2018;215:509)
- Adjuvant chemotherapy less effective for lobular carcinoma (Oncol Ther 2020;8:1)
- Response to hormone therapy superior to invasive breast carcinoma of no special type (Eur J Cancer 2008;44:73)
- Benefit from radiotherapy similar to invasive breast carcinoma of no special type (Clin Breast Cancer 2016;16:319)
Gross description
- Can form a discrete irregular mass (BMJ Case Rep 2016;2016:bcr2016215665)
- Frequently ill defined borders, due to lack of sclerotic stromal response
- Not uncommonly grossly unidentifiable or is grossly underestimated, only slightly firm on palpation
Frozen section description
- Discohesive tumor cells may be difficult to identify on frozen sections, particularly when cellularity is low
- Single tumor cells can be mistaken as inflammatory cells (histiocytes and lymphocytes) and vice versa
- Ill defined nature of lesion increases chance of margins sent for frozen section being involved by tumor microscopically
Microscopic (histologic) description
- Tumor cells arranged in single files, cords and single cells (Breast Cancer Res 2015;17:12)
- Can be arranged concentrically around normal ducts, giving a targetoid appearance
- Tumor cells discohesive, small, monomorphic and lacking marked atypia
- Round or notched ovoid nuclei, usually grade 1 or 2 nuclear score
- Scant cytoplasm, occasional with intracytoplasmic lumen
- Mitosis infrequent
- Desmoplastic reaction and necrosis uncommon
- Requires high index of suspicion for metastasis
- Single and scattered tumor cells with mild atypia requires examination on high power magnification with caution (Int J Surg Case Rep 2021;80:105612)
- Other (nonclassic) patterns of lobular carcinoma
- Solid:
- Sheets or large nests of tumor cells
- Alveolar:
- Clusters and aggregates of ≥ 20 cells
- Tubulolobular carcinoma:
- Tumor cells arranged in small round tubules mixed with classical lobular carcinoma
- Pleomorphic:
- Markedly pleomorphic (nuclear size > 4 times lymphocyte or nuclear pleomorphism equivalent to high grade ductal carcinoma in situ)
- Higher rate of hormone receptor negativity, HER2 and p53 immunohistochemistry positivity
- Histiocytoid:
- Foamy cytoplasm resembling histiocytes
- Apocrine:
- Abundant eosinophilic granular cytoplasm
- Signet ring
- Solid:
Microscopic (histologic) images
Cytology description
- Cellularity can be low
- Tumor cells arranged in chains, single files or as single cells
- Tumor cells arranged in small chains are helpful clues
- Nuclear atypia mostly mild
- Nuclei round to oval and eccentric
- Cytoplasm scanty with a high nuclear / cytoplasmic ratio
- Occasional intracytoplasmic vacuolations may be seen
- Cytologic features can resemble mesothelial cells in effusion fluid (Diagn Cytopathol 2012;40:311)
Cytology images
Positive stains
- Estrogen receptor (97%) and progesterone receptor (80%) (Breast Cancer Res Treat 2012;133:713)
- Androgen receptor (87%) (Virchows Arch 2005;447:695)
- Abnormal expression of catenins
- p120 (88%) (cytoplasmic) (Oncogene 2004;23:3272)
- Beta catenin (42% nuclear and cytoplasmic; 23% retained membranous staining) (Eur J Surg Oncol 2001;27:31)
- GATA3 (97 - 100%) (Am J Surg Pathol 2013;37:1756, Ann Diagn Pathol 2015;19:6)
- Mammaglobin (69%) (Ann Diagn Pathol 2015;19:6)
- GCDFP-15 (52%) (BMC Cancer 2014;14:546)
- Mucicarmine (highlights intracellular mucin)
Negative stains
- Abnormal expression of catenins
- E-cadherin (16%) (Am J Surg Pathol 2010;34:1472, Hum Pathol 2020;102:44)
- E-cadherin absence or reduction of membranous staining, useful but not necessary for diagnosis of lobular carcinoma
- Beta catenin (35% lost) (Eur J Surg Oncol 2001;27:31)
- E-cadherin (16%) (Am J Surg Pathol 2010;34:1472, Hum Pathol 2020;102:44)
- HER2 (1 - 11%) (Annals of Oncology 2018;29: ix1)
Molecular / cytogenetics description
- Mostly luminal A subtype by gene expression profiling (Cell 2015;163:506)
- Followed by luminal B but rarely HER2 enriched or basal-like
- 1q gain, 16p gain and 16q loss frequent (J Pathol 2008;215:231)
- CDH1 gene located at 16q22.1 (Br J Cancer. 1997;76(9):1131-1133)
- CDH1 (65%) and PIK3CA (48%) mutations common (Cell 2015;163:506)
- CDH1 loss of function through truncating mutation or promoter hypermethylation combined with loss of heterozygosity at chromosome 16, resulting in loss of protein (Int J Cancer 2001;92:404, Int J Cancer. 2003;106(2):208-215, Breast Cancer Res 2015;17:12)
Sample pathology report
- Left breast, mastectomy:
- Invasive lobular carcinoma (see comment)
- Comment: Sections show breast tissue with malignant cells in a diffuse and discohesive pattern, with some forming single files and small clusters. Targetoid pattern is noted. The tumor cells show mild nuclear pleomorphism with rare mitoses, corresponding to a Nottingham histological grade of I. No lymphovascular permeation is seen. The tumor measures ___cm in maximal dimension. The remaining breast tissue and nipple are unremarkable. All the resection margins are clear, with a minimal clearance of ___cm at the ___ margin. Immunohistochemical staining shows tumor cells are E-cadherin negative. The features are those of an infiltrating lobular carcinoma, classic type.
Differential diagnosis
- Primary disease
- Mixed invasive breast carcinoma and invasive lobular carcinoma:
- Presence of ductal component
- Lobular component more commonly E-cadherin positive (92%) (Breast Cancer Res Treat 2013;138:719)
- Lobular carcinoma in situ involving sclerosing adenosis:
- Retained lobular architecture
- Myoepithelial cells present and can be demonstrated by immunohistochemistry
- Inflammatory infiltrates and lymphoma:
- Lacks background lobular carcinoma in situ
- Lymphoid cells may be more hyperchromatic and have less cytoplasm
- No intracellular cytoplasmic vacuolation
- Cytokeratin negative and lymphocyte markers positive
- Melanoma:
- Lacks background lobular carcinoma in situ
- Can display marked nuclear atypia
- Cytokeratin negative and melanocytic markers positive
- Myofibroblastoma, epithelioid variant:
- Well circumscribed borders
- Lacks background lobular carcinoma in situ
- Presence of spindle cell component
- Cytokeratin negative
- Mixed invasive breast carcinoma and invasive lobular carcinoma:
- Metastatic disease
- Histiocytes and lymphocytes
- Signet ring cell carcinoma of gastrointestinal origin:
Practice question #1
Which of the following germline mutations is associated with an increased risk of developing lobular carcinoma of the breast?
- APC
- BRCA1
- BRCA2
- CDH1
- TP53
Practice answer #1
D. CDH1. CDH1 encodes E-cadherin and germline mutation results in hereditary diffuse gastric cancer syndrome. No increased risk of developing lobular carcinoma of the breast is reported for germline BRCA1 and BRCA2 mutations. Germline TP53 and APC mutations result in Li-Fraumeni syndrome and familial adenomatous polyposis, which are not associated with lobular carcinoma of the breast. (Cancer Epidemiol Biomarkers Prev 2012;21:134, Breast J 2019;25:16)
Comment Here
Reference: Classic lobular carcinoma
Comment Here
Reference: Classic lobular carcinoma
Practice question #2
Which of the following features is more commonly seen in classic lobular carcinoma compared with pleomorphic lobular carcinoma?
- Formation of invasive tubular structures
- Grade 3 (markedly pleomorphic) nuclear features
- HER2 positivity
- Hormone receptor positivity
- TP53 mutation
Practice answer #2
D. Hormone receptor positivity. Compared with classic lobular carcinoma, pleomorphic lobular carcinoma is more likely to be HER2 positive, hormone negative and TP53 mutated. Marked nuclear pleomorphism is a required feature of pleomorphic lobular carcinoma. Neither classic nor pleomorphic lobular carcinoma feature glandular formation. (Cell Oncol (Dordr) 2012;35:111)
Comment Here
Reference: Classic lobular carcinoma
Comment Here
Reference: Classic lobular carcinoma